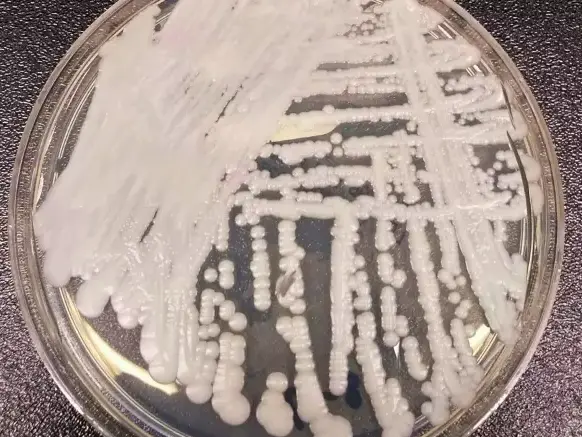
У смертоносного грибка обнаружили половое размножение.  Так он становится опаснее

У смертоносного грибка обнаружили половое размножение. Так он становится опаснее
В 2009 году у 70-летней японки обнаружили неизвестные ранее дрожжевые грибки. Эти организмы под названием Candida auris распространились и стали представлять угрозу для общественного здоровья. Главная особенность грибков в том, что они устойчивы ко многим лекарствам. Теперь учёные обнаружили, что проблема может быть хуже, чем все думали.
В норме дрожжи размножаются бесполым путём. Но исследователи из Макмастерского университета в Канаде обнаружили признаки полового размножения у C. auris. Это может привести к появлению более устойчивых к лекарствам и вирулентных штаммов грибка.
Дело в том, что при половом размножении происходит рекомбинация, то есть перетасовка генетической информации. Это позволяет организму лучше адаптироваться к изменяющимся условиям.
Несмотря на то, что, похоже, не все грибки C. auris способны спариваться, даже нечастые такие случаи могут потенциально обеспечить резистентность к лекарствам и сделать патоген хуже для людей.
Comments are closed.